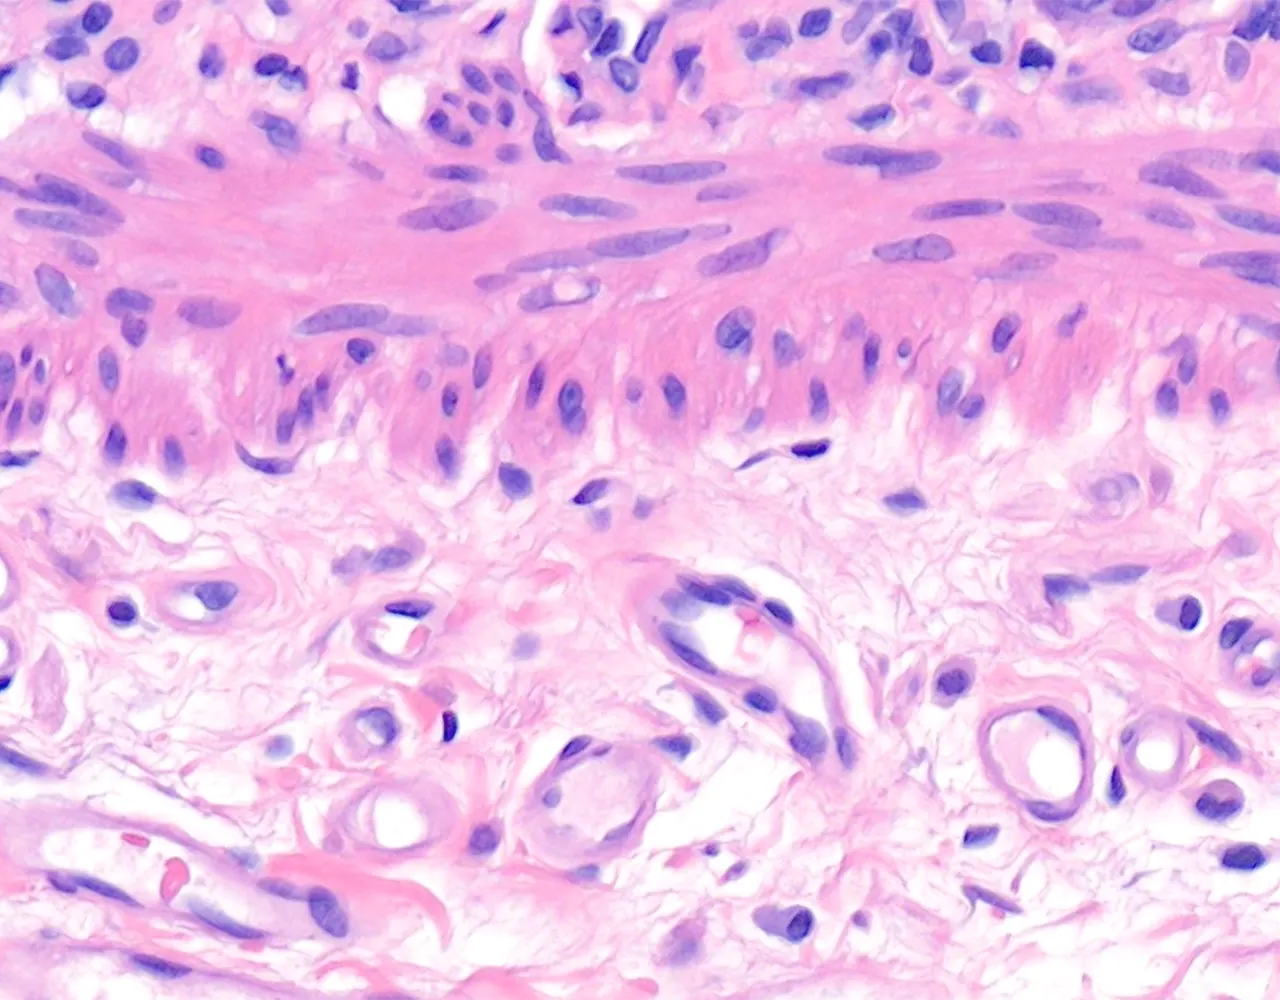

Généralités
- Le gros intestin comprend le caecum, le côlon, le rectum et le canal anal.
- Le côlon droit comprend la valvule iléo-caecale, le caecum, le côlon ascendant, l’angle hépatique et la portion proximale du côlon transverse.
- Le côlon gauche comprend la portion distale du côlon transverse, l’angle splénique, le côlon descendant, le côlon sigmoïde et le rectum.
- Le côlon ascendant et le côlon descendant sont majoritairement rétropéritonéaux, alors que le côlon transverse et le côlon sigmoïde sont intrapéritonéaux et recouverts par la séreuse.
- Le rectum est partiellement recouvert par une séreuse dans sa portion proximale, le reste du rectum est entouré par une adventice.
- Functions :
- Le gros intestin est responsable de l’absorption de l’eau et des électrolytes, de la sécrétion de mucus pour la lubrification, de la compaction et du stockage des matières fécales, ainsi que de la contribution aux interactions entre l’hôte et le microbiote.
- L’appendice est un diverticule borgne naissant du caecum.
- Il contribue principalement à la fonction immunitaire locale grâce à son abondant tissu lymphoïde et peut également agir comme réservoir du microbiote intestinal normal.






.webp)











-p-130x130q80.png)


.webp)